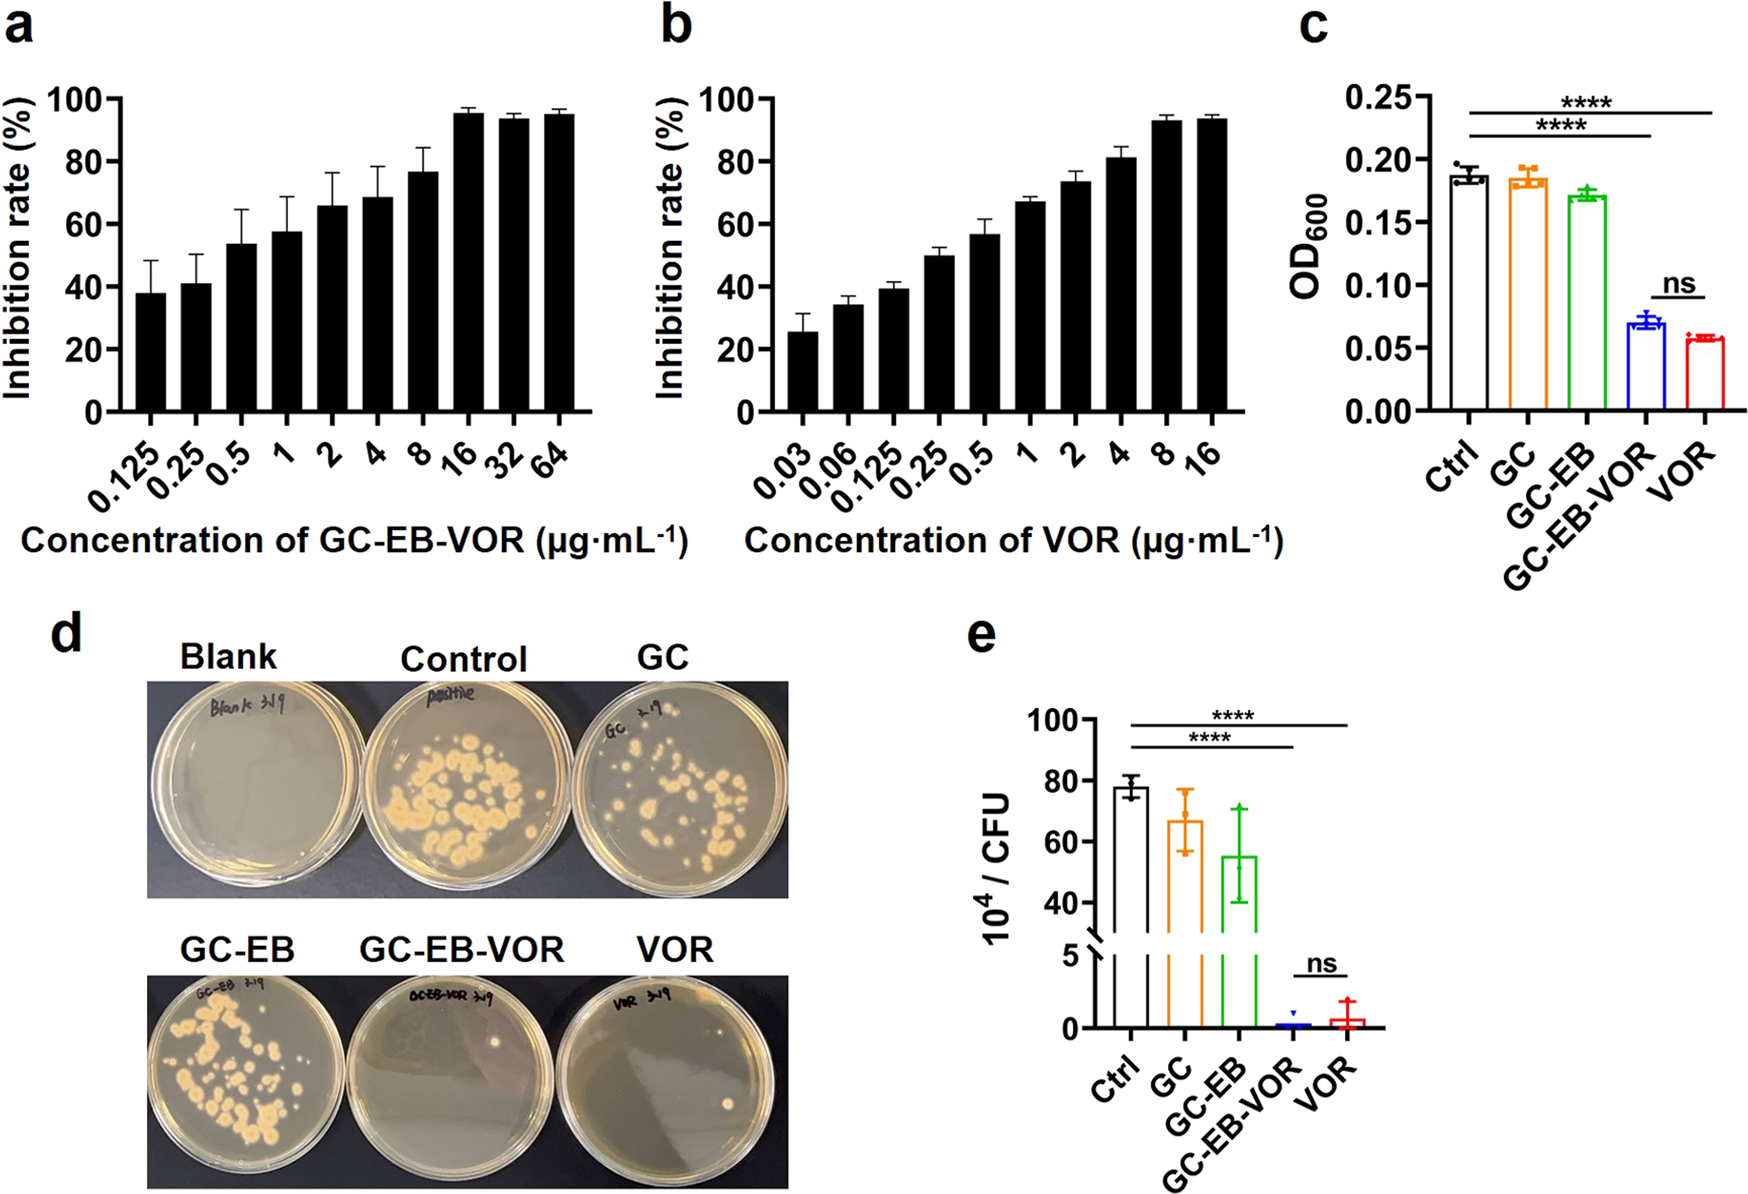
Fig. 4

Fig. 4: In vitro antifungal evaluation of GC-EB-VOR against Fusarium.
a, b The inhibition rates of Fusarium by GC-EB-VOR and VOR treatment for 48 h at different concentrations. c Optical density at 600 nm (OD600) of Fusarium suspensions after different treatments for 48 h. The concentrations of GC, GC-EB, and GC-EB-VOR were 16 µg/mL, while the concentration of VOR was 11 µg/mL based on a loading rate conversion. d Representative photographs of microorganism colony-forming units (CFU) after adding 100 µL of 16 µg/mL (determined using an OD600 assay) of growth suspension (1:104 dilution) of Fusarium, followed by treatment with GC, GC-EB, GC-EB-VOR or VOR for 48 h. e Relative quantitative results for Fusarium CFU. Data are represented as the means ± SDs from three independent experiments. ****P < 0.0001.